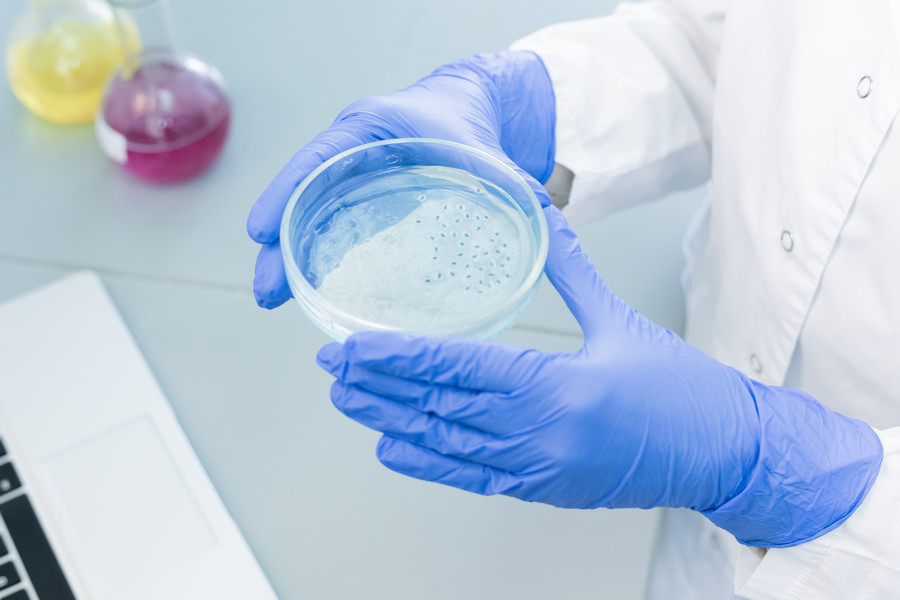
Клеточная культура Клеточная культура

Новая компания Стартап-студии БФУ ООО «Балтик-БиотехР» займется разработкой и производством специальной добавки для питательной среды, в которой выращивают клетки, об этом сообщает пресс-служба БФУ. Для науки и производства этот метод решает массу задач, как исследовательских, так и прикладных. Главное преимущество культивируемых клеток — это возможность прижизненного наблюдения за ними с помощью микроскопа. С помощью метода наращивания клеток ученые производят противовирусные вакцины, лекарственные препараты и БАДы, это незаменимая часть регенеративной медицины для восстановления тканей, создания противоопухолевых клеточных препаратов, лечения аутоиммунных и аллергических заболеваний.
Трофико-пролиферативная добавка, предложенная стартаперами БФУ, значительно повысит эффективность клеточного масштабирования.
«В разработанной технологии оптимизирован процесс получения добавки. Производственное время сократилось в десять раз и, как следствие, снижаются затраты на производство — расход электричества, количество рабочих часов лаборанта, расходные материалы. В качестве материала мы используем технологические остатки, полученные при переработке донорской крови. В процессе активации и очистки создается биологически активная добавка. Благодаря этому объем продукта на выходе минимум в четыре раза больше, чем при стандартном методе из цельной крови. Технологический процесс обеспечивает полное сохранение биологически активных компонентов», — рассказала генеральный директор ООО «БалтикБиотехР», старший научный сотрудник Центра иммунологии и клеточных биотехнологий БФУ им. И. Канта Валерия Шуплецова.
Технологическим партнером компании ООО «БалтикБиотехР» выступила Станция переливания крови Калининградской области.
Техпредприниматели получили первые лабораторные образцы и изучили, как продукт влияет на различные клетки человека.
«Результаты показали положительное влияние на процесс деления, морфологию и функционирование клеток. На данном этапе наша команда, в которую вошли сотрудники Центра иммунологии и клеточных биотехнологий и магистранты Высшей школы бизнеса и предпринимательства БФУ, проектирует пилотную производственную линию и проводит маркетинговые исследования», — уточнила Валерия Шуплецова.
Как отметила замдиректора Стартап-студии БФУ Елена Кабакова, производство клеточных культур является неотъемлемой частью медицинских исследований и разработки лекарств.
«Ожидается, что среднегодовой темп роста рынка клеточных культур составит 11% до 2027 года. Большой толчок рынку клеточных биотехнологий дала пандемия COVID-19. Фармацевтические фирмы, правительственные организации в разных странах и научно-исследовательские институты начали сосредотачиваться на разработке эффективных вакцин и новых терапевтических средств для преодоления ситуации. Клеточная культура может служить потенциальной платформой для разработки новых вакцин для лечения. Уверены, разработка компании «Балтик-БиотехР» будет актуальна для отечественных научных и производственных групп, которые занимаются созданием клеточных продуктов, разработкой и производством вакцин», — подчеркнула эксперт.